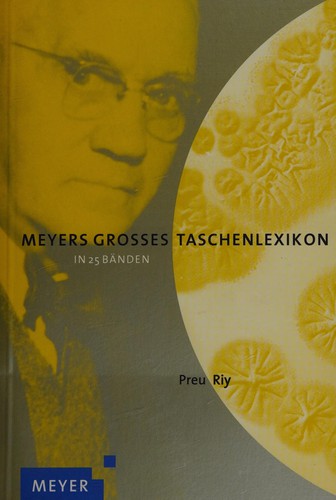
Meyers großes Taschenlexikon, 25 Bde. m. CD-ROM (Standardausg.), Bd.18, Preu-Riy

A practical essay on the disease generally known under the denomination of delirium tremens

Modern volleyball; for teacher, coach and player

Meyers großes Taschenlexikon, 25 Bde. m. CD-ROM (Standardausg.), Bd.18, Preu-Riy

Sport with gun and rod in American woods and waters

Français

Bertelsmann Musikführer

Enciclopedia médica práctica

African parrots

A new dictionary of the Latin and English languages

Usi e costumi sociali, politici e religiosi di tutti i popoli del mondo

Student Press and the Hazelwood Decision

Folk Music of the Hungarians

Semi-annual wholesale price list of the Shenandoah Nursery

Wu ye guan li gong gong guan xi

The story of architecture in England.

Introduction to music education

Deutsch-österreichische Politik

The exceptional child.

Paintings and water colors by the most eminent masters

Disabled people as second-class citizens

Breakfasts and teas

Annalen der Literatur und Kunst des In- und Auslandes

School reports and school efficiency.

Etymologisches wörterbuch der rumänischen sprache ...

Antiquities

The multi-level and polycentric European Union

Study Guide for Maternal-Child Nursing

Instruction book for the standard tailor system ...

Webster's official crossword puzzle dictionary.

Haydn, solo piano literature

Pheasants

Mawa: Mentoring Artists for Women's Art

Anthropometry of the Ovimbundu, Angola

The complete book of parties, celebrations and special occasions

New plays by women

Plays from African tales

Superplanes

Plants of the Hedgerow

Visual vegetables

Uchebnik ugolevnago prava.

Revise AS Sociology OCR

An introduction to Romance linguistics